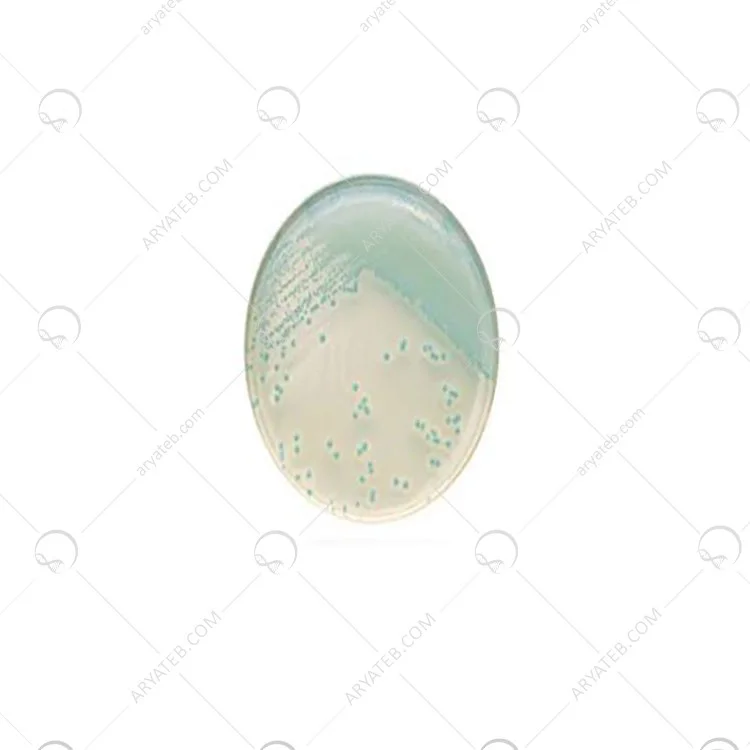

محیط کشت کروم آگار لیستریا
- برای جلوگیری از آلودگی غذا به میکروب Q.C در نظر گرفته شده است.
محیط کشت Chromagar Listeria Base
محیط کشت Chrom Agar Listeria Base ، که ترجمه فارسی محیط کشت پایه کروم آگار لیستریا است. این محیط کشت یکی دیگر از محیط های کشت می باشد که برای مطالعه و دستیابی به هدف مورد نظر تدوین شده است. همانطور که می دانید ، مدل های از محیط کشت وجود دارد که هر یک از آنها فرمول ها و ساختارهای گوناگونی دارند و می توان از آنها برای آزمایش در محیط استفاده کرد.
محیط کشت کروم آگار لیستریا Chromagar Listeria Base
و چه کاربردی دارد
محیط لیستریا کروم آگار یک محیط کروموژنیک می باشد که برای تجزیه ، جداسازی و شمارش L. monocytogenes استفاده می شود. لیستریا مونوسیتوژنز باکتری وسیعی میباشد که در خاک ، فاضلاب یا مدفوع یافت می شود. توانایی تشکیل زیست توده لیست. این عامل بیماری زا می تواند باعث مسمومیت شدید غذایی شود و بنابراین بیشتر برای ایجاد امکانات پردازش غذا برای پیشگیری از آلودگی غذا به میکروب Q.C در نظر گرفته شده است. در غیر این صورت ، آلودگی می تواند در تمام مراحل رژیم غذایی رخ دهد.
در شرایط بالینی ، جداسازی L. monocytogenes می تواند در نمونه هایی با منشاء انسانی مانند کشت خون و CSF از این محیط استفاده شود.
ترکیبات محیط کشت کروم آگار لیستریا
.jpg)
محیط کشت Chrom Agar Listeria Base
- 5/51 گرم پودر شده را به آرامی در 1 لیتر آب خالص حل کنید.
- ترکیب باید غلظت بالایی داشته باشد.
- مخلوط را به مدت 15 دقیقه در دمای 121 درجه سانتی گراد گرم کنید.
- در حمام آب تا 47 درجه سانتیگراد سرد کنید.
آدرس ایمیل شما منتشر نخواهد شد. فیلدهای الزامی علامت گذاری شده اند *